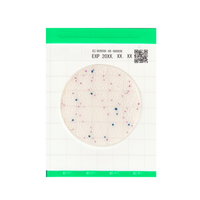
Easy Plate EC (E. Coli / Coliformes) | Placa de medios preparados - Kikkoman

Easy Plate EC (E. Coli / Coliformes) | 25 Placas de medios preparados - Kikkoman

Pague en línea de forma 100% segura con el respaldo de Wompi
Easy Plate es una placa de medios preparados que no requiere preparación ni esterilización. Utilizando una metodología de medios de cultivo probada y validada por AOAC RI PTM, MicroVal y NordVal (la certificación de AOAC RI PTM, MicroVal y NordVal para Easy Plate EB y AC-R está pendiente), Easy Plate viene en un formato de placa de película apilable y fácil de usar que ahorra espacio, reduce el desperdicio, elimina el tiempo y la mano de obra de preparación, y agiliza sus procedimientos de prueba
Easy Plate EC es una formulación de medio personalizada con certificación AOAC PTM para la detección, identificación y enumeración de coliformes E. coli y no E. coli . Un kit de prueba microbiana que incluye dos sustratos cromogénicos que hacen que E. coli exhiba un color azul-púrpura a azul marino, mientras que los coliformes no E. coli exhiban un color rosa a rojo-púrpura, lo que le permite distinguir cada uno en su análisis* en aproximadamente 24 horas.
La coloración distintiva de las colonias ayuda a superar las interferencias comunes en las pruebas de alimentos y agua para facilitar el análisis y la enumeración de E. coli y coliformes. Si bien la mayoría de las E. coli producen β-glucuronidasa, E. coli O157 no produce específicamente β-glucuronidasa y, por lo tanto, exhibe un color rojo-púrpura similar al de los coliformes no E. coli.
Esto debe tenerse en cuenta en su análisis y conclusiones. Easy Plate EC cuenta con certificación AOAC PTM y se debe almacenar sin abrir a 2-8 ℃.
ESPECIFICACIONES DEL PRODUCTO
| Nombre del producto | Plato Fácil EC |
|---|---|
| Código del producto | 61975 |
| Microorganismo objeto | E. coli y coliformes |
| Tiempos de incubación | 24 ± 1 horas |
| Temperatura de incubación | 35 ± 1 °C |
| Condiciones de almacenamiento (sin abrir) | 2 - 8 °C |
| (Después de abrir) | Después de abrir el paquete, doble el extremo abierto del paquete al menos 2 veces y fíjelo con cinta adhesiva. Conservar en el refrigerador (de 2 a 8 °C) y consumir en un plazo de 3 meses |
CARACTERÍSTICAS
1. Colonias de colores brillantes a las 24 horas.
- Las pruebas convencionales que utilizan agar tradicional o medios líquidos se pueden reemplazar con una hoja de medio Easy Plate.
- La identificación y el recuento de colonias es más fácil en comparación con otros medios, como el agar tradicional, ya que las colonias coloreadas hacen innecesario confirmar la presencia o ausencia de burbujas de aire o el tamaño de las colonias.

2. Alta correlación con el agar de recuento en placa.
Alta correlación con el agar de recuento en placa en varios alimentos.

COLORACIÓN
Colonias de E. coli O157:H7
Si bien la mayoría de las bacterias E. coli producen β-glucuronidasa, E. coli O157:H7 no produce específicamente β-glucuronidasa y, por lo tanto, exhibe un color rojo violeta similar al de los coliformes.

Coloración de la superficie de la placa causada por enzimas contenidas en los alimentos
En algunos alimentos y productos lácteos no calentados, las enzimas residuales pueden causar una coloración rojo-violeta en toda el área de incubación. Si la visibilidad de las colonias se ve afectada, se puede mejorar mediante diluciones.
Con una rica historia arraigada en la biotecnología y la fermentación, la compañía ha sabido trasladar su experiencia a soluciones innovadoras para la monitorización de la higiene.
Sus kits para la monitorización de superficies, como el sistema ATP A3 con el Lumitester Smart y los hisopos LuciPac, representan un avance significativo en la detección rápida y eficaz de residuos orgánicos, incluyendo ATP, ADP y AMP.
Esta tecnología permite a las empresas del sector alimentario verificar la eficacia de sus protocolos de limpieza y saneamiento en tiempo real, previniendo la contaminación cruzada y garantizando la seguridad de los alimentos.
La importancia de Kikkoman Biochemifa en la industria alimentaria radica en su compromiso con la mejora continua de la seguridad alimentaria. Sus soluciones no solo facilitan el cumplimiento de las normativas y estándares internacionales como HACCP y FSSC 22000, sino que también empoderan a las empresas para adoptar un enfoque proactivo en la gestión de la higiene.
Al proporcionar herramientas de detección sensibles y fáciles de usar, Kikkoman Biochemifa contribuye a proteger la salud del consumidor y a mantener la confianza en la cadena de suministro alimentaria global.